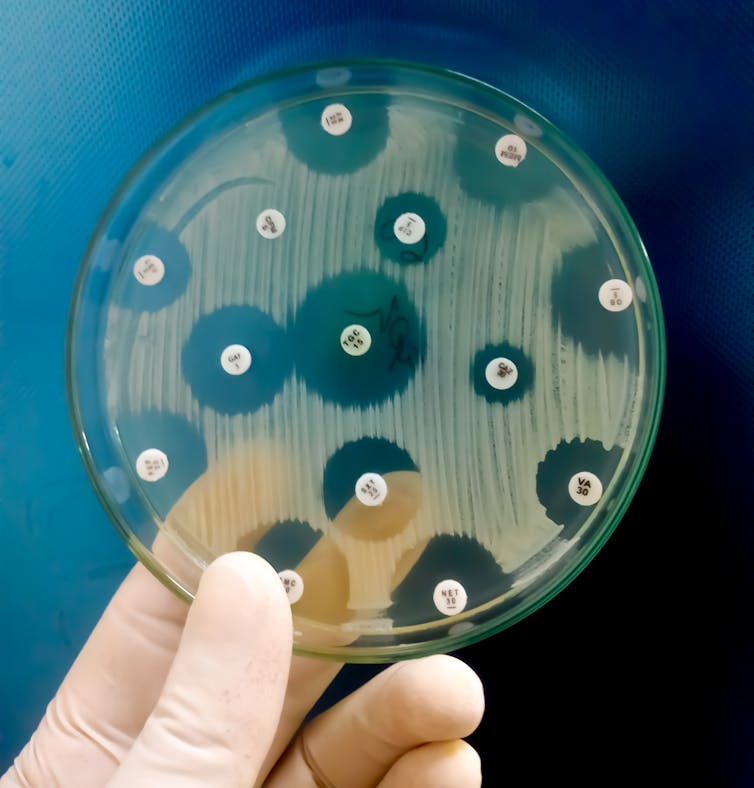
Hand holding a petri dish containing bacteria.

The triumph of COVID-19 vaccine development and the discovery of effective treatments was only possible because of the unprecedented coordination of clinical trials. A process of testing – that often lasts over a decade – was compressed into less than nine months. This should now be the model for other major planetary health crises – namely, antimicrobial resistance (AMR).
To stay ahead of, and rapidly respond to, non-viral microbial threats, we believe it is time for a new forward-looking clinical trials infrastructure. A network of public clinical trials institutes could permanently connect pre-clinical academic ingenuity with the best of post-clinical commercial savvy and replenish the empty pipeline for new antibiotics. Action is urgently needed. That was the conclusion of a study we conducted with Adam Roberts, at the Liverpool School of Tropical Medicine, and Andrew Singer, at the UK Centre for Ecology and Hydrology.
AMR – the natural process whereby bacteria adapt to resist the antibiotics used to control them – poses a grave threat to global health and food production systems. Tens of thousands of people are already dying and many more are suffering from infections that were once treatable, and the problem is growing quickly.
Part of the solution lies in taking better care of the antibiotics we already have at our disposal. Every time an antibiotic is used, it creates an evolutionary advantage for bacteria that can withstand its effects. Over time, this leads to a resistant bacterial population. So antibiotics are a time-limited resource that must be used sparingly.
Bacteria have evolved resistance to every antibiotic ever developed. For example, it took just six years for resistance to penicillin, the first antibiotic, to become widespread in British hospitals.

The other part of the solution lies in stimulating the antibiotic research and development pipeline for new antibiotics.
Read more: Scientists around the world are already fighting the next pandemic
Luring investors
But there are well-known economic barriers to commercial antibiotic research and development. The most important is that research, trials and licensing of new drugs is expensive – but new antibiotics yield less profit than drugs for cancer or chronic conditions and need to be protected from overuse to prevent resistance.
There is also no guarantee that investing in a promising compound that was discovered during pre-clinical research will translate into a viable drug. Currently, around 95% of promising pre-clinical compounds that enter human trials do not make it through the so-called “valley of death” of clinical trials to regulatory approval.
This is because some compounds show little or no effect, others have side-effects, and some developers are unable to attract and sustain the levels of investment that are necessary to finance expensive clinical trials, which can take over 13 years. Many more research projects fail before they even get tested in humans.
Faced with so many risks and less attractive profit outlooks than with other drugs, why would any commercial developer invest in antibiotic research?
To lure commercial investors back into the fold, Britain, the US and the EU have invested more than US$1.5 billion of public money to subsidise early-stage research and increase the financial yield of antibiotics that make it through trials.
At the recent G7 meeting, the UK tried to promote a so-called antibiotic subscription model, which it had implemented in 2020. Similar to Netflix, governments would no longer pay industry per antibiotic pill used (as they do now) but for the value of that pill to society. It is hoped that guaranteed profits and minimised investment risks will entice large pharmaceutical companies to reinvest in research and development.
So far, the success of traditional market-centred subsidies has been limited and G7 members did not explicitly commit to the UK subscription model. Although they did agree to explore further strengthening of market incentives.
Learning from COVID-19
With a global surge of antimicrobial-resistant organisms already upon us and COVID-19 placing further pressure on existing antibiotics as a result of co- and secondary infections, we urgently need new creative approaches to refilling the pipeline.
One solution may be to turn the existing subsidy model for new antibiotics on its head. Rather than putting all eggs in one basket and funding individual companies with drugs that may or may not make it through the valley of death, we propose building a bridge to cross this valley with a network of public institutes. These institutes would be capable of carrying out clinical trials and producing limited amounts of experimental antibiotics. They could essentially fix the broken pipeline.
A dedicated antibiotic clinical trials infrastructure would combine the best of public and private sector knowhow. Intellectual property resulting from public research would stay in the public’s hands and academics could take full credit for their discoveries by publishing results rather than waiting for patent applications to be filed.
In addition to protecting compounds from commercial failure and disappearing behind patent barriers, a permanent network of clinical trial institutes could also decrease the cost and increase the quality of the trials.
At the moment, developers have to attract large amounts of venture capital to fund commercial trials. Dedicated antibiotic trials institutes would de-risk this process, build human expertise in trialling drugs and significantly lower research and development costs for public and private developers.
By making access to public trials networks dependent on targeting priority pathogens identified by the World Health Organization, pre-clinical research and development would be incentivised to target the most pressing and – not just the most profitable – health issues. Meanwhile, clinical trials could take place in the low-income areas where new antibiotics are most needed.
At the end of a clinical trial, industry could be commissioned to do what it does best: manufacture and distribute. Similar to other public services provided by for-profit companies, new drugs could be distributed by commercial manufacturers capable of guaranteeing environmentally sound production and accessible drug prices.
Long-term supply contracts for healthcare providers and a repurposing of existing antibiotic subscription models in the UK and Sweden could easily be used to entice bidding by manufacturers and guarantee commercially viable production of new drugs.
The global COVID vaccine response has revealed the importance of forward-looking public infrastructure and research investment to stay ahead of and rapidly respond to microbial threats.
A network of public clinical trials institutes for antibiotics could do just that and benefit both public and commercial developers in the process. After over 30 years of stalling innovation and stop-start subsidies, this could permanently bridge the trials gap.
This article is part of a series on recovering from the pandemic in a way that makes societies more resilient and able to deal with future challenges. Read more of the coverage here.

